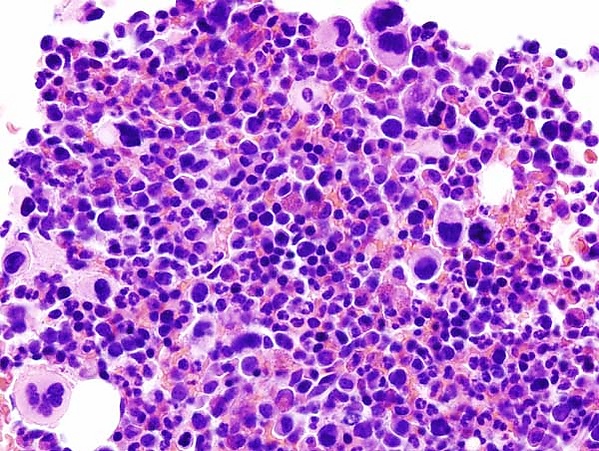

Эссенциальная тромбоцитемия
Эссенциальная тромбоцитемия — это заболевание крови из категории миелопролиферативных заболеваний. Его основной признак — повышенное количество тромбоцитов в периферической крови, вызванный избыточным клональным разрастанием мегакариоцитарного ростка в системе кроветворения[3].
Общие сведения
История
Эссенциальная тромбоцитемия (ЭТ) впервые была описана в 1934 году и первоначально названа геморрагической тромбоцитемией. В 1951 г. американский гематолог русского происхождения Уильям Дамешек выделил из группы хронических опухолей костного мозга заболевание, характеризующееся повышением в крови количества тромбоцитов, и назвал его «мегакариоцитарная лейкемия». В последующем опухоль получала названия «хронический мегакариоцитарный лейкоз», «геморрагическая тромбоцитемия»[4][5].
Классификация
ЭТ относится к группе миелопролиферативных заболеваний, ассоциированных с мутацией в гене янус-киназы 2 (JAK2), наряду с истинной полицитемией, первичным миелофиброзом и не классифицируемыми миелопролиферативными заболеваниями[6].
Этиология и патогенез
Основной причиной ЭТ является гиперпродукция гемопоэтических клеток, обусловленная мутациями в генах JAK2, CALR или MPL. Мутации в этих генах называют «драйверными мутациями», поскольку они играют ключевую роль в развитии миелопролиферативного заболевания. Хотя 90 % взрослых пациентов имеют мутации JAK2, CALR или MPL, у детей нередко встречается тройной негативный статус по этим маркерам.
Распределение мутаций имеет возрастные особенности. Мутация V617F в гене JAK2 встречается примерно у половины пациентов с ЭТ. Этот ген отвечает за синтез белка Jak2, входящего в группу внутриклеточных ферментов — янус-тирозинкиназ. В клетках красного костного мозга Jak2 взаимодействует с рецепторами различных веществ, включая рецептор тромбопоэтина. Тромбопоэтин играет ключевую роль в делении и созревании мегакариоцитов — клеток-предшественников тромбоциты. В норме Jak2 активируется и запускает сигнальный каскад, стимулирующий рост и созревание клеток, только при связывании лигандов с соответствующими рецепторами. Однако мутация V617F вызывает конститутивную активацию Jak2, что приводит к непрерывной выработке тромбоцитов даже без стимуляции рецепторов тромбопоэтина.
Мутация CALR (кальретикулин; 19p13.2) обнаруживается у четверти пациентов с ЭТ. Этот ген расположен вблизи локусов, отвечающих за продукцию тромбоцитов. Кальретикулин является многофункциональным кальций-связывающим белком и чаще встречается у молодых пациентов, характеризуясь более высоким уровнем тромбоцитов, но меньшим риском тромбозов. Мутантный кальретикулин способен изменять структуру рецептора тромбопоэтина, что приводит к активации Jak2 и избыточному образованию тромбоцитов.
Мутация MPL (онкоген миелопролиферативного лейкоза; 1p34) встречается у 4-5 % пациентов с ЭТ и ассоциирована с лейкемической трансформацией[5].
Диагностика
Клиническая картина
У пациентов с ЭТ клинические проявления могут варьироваться. При бессимптомном течении тромбоцитоз обычно становится случайной находкой в общем анализе крови. Среди наиболее частных симптомов выделяют бессонницу, мигрень, головные боли и головокружение. Также могут наблюдаться тромбозы различной локализации, включая тромбоз печёночных вен — один из характерных признаков заболевания. Другие возможные проявления включают транзиторные ишемические атаки, эритромелалгию и повышенную склонность к образованию синяков. Наиболее частый объективный признак при ЭТ — спленомегалия, которая, однако, выражена слабее, чем при других миелопролиферативных заболеваниях[5].
Лабораторная диагностика
Общий анализ крови: характерны тромбоцитоз, анизоцитоз тромбоцитов, спонтанная агрегация тромбоцитов, агрегация тромбоцитов с лейкоцитами.
Микроскопия мазка крови: характерны морфологические аномалии тромбоцитов в виде уменьшение количества α-гранул, аномалии псевдоподий, трубочек и открытой канальцевой системы. Сами тромбоциты гигантских размеров.
Молекулярно-генетический анализ: выявление мутаций в генах JAK2, CALR или MPL[7].
Инструментальная диагностика
Цитологическое исследование биоптата костного мозга: обычно выявляется нормоклеточность с увеличением количества мегакариоцитов. Характерные особенности мегакариоцитов включают:
- крупные или гигантские размеры;
- выраженная гиперлобуляция ядер;
- распределение в виде «рыхлых» скоплений;
- плотные кластеры мегакариоцитов встречаются редко[6].
Диагностические критерии ЭТ по Международной Консенсусной Классификации (для установления диагноза требуется наличие всех 4 больших критериев или 3 больших и 1 малого критерия):
- большие диагностические критерии:
- Количество тромбоцитов ≥450×10⁹/л
- Изменения в костном мозге:
- пролиферация зрелых мегакариоцитов;
- гиперсегментированные ядра;
- расположение мегакариоцитов в виде рыхлых скоплений;
- отсутствие фиброза или фиброз 1 степени (по шкале оценки).
- Отсутствие критериев других миелопролиферативных заболеваний.
- Наличие мутаций: JAK2, CALR или MPL
Малые диагностические критерии
- наличие другого клонального маркера
- отсутствие признаков реактивного тромбоцитоза[6].
Дифференциальная диагностика
Дифференциальная диагностика ЭТ включает:
- Миелопролиферативные заболевания:
- истинная полицитемия;
- первичный миелофиброз;
- хронический миелолейкоз.
- Реактивные тромбоцитозы на фоне следующих состояний:
- инфекционные заболевания;
- воспалительные процессы;
- тканевое повреждение (послеоперационные состояния, травмы);
- гипоспленизм;
- железодефицитная анемия;
- онкологические заболевания;
- гемолиз.
- Наследственные формы:
Осложнения
Тромбозы развиваются у 20 % пациентов, тогда как геморрагические осложнения встречаются в 10 % случаев. Тромбозы при этом заболевании могут поражать различные сосудистые бассейны. При вовлечении церебральных сосудов развиваются транзиторные ишемические атаки или инсульты, при тромбозе коронарных артерий возникает острый коронарный синдром, а поражение печёночных вен приводит к развитию синдрома Бадда — Киари.
У детей с ЭТ как тромботические, так и геморрагические осложнения встречаются значительно реже. Что касается риска лейкозной трансформации, то у взрослых пациентов он составляет 2-3 % в течение первых 10 лет заболевания и достигает 5 % к 15 годам наблюдения, тогда как у детей подобная трансформация происходит крайне редко.
Отдельного внимания заслуживают осложнения беременности у пациенток с ЭТ. К ним относятся эклампсия, преждевременная отслойка плаценты, задержка внутриутробного развития плода и мертворождение. Эти осложнения связаны с нарушением микроциркуляции в плацентарном ложе и требуют особого подхода к ведению беременности у данной категории пациенток[5].
Лечение
Основной целью терапии ЭТ является профилактика тромботических и геморрагических осложнений, которые остаются главными причинами инвалидизации и смертности пациентов. Для определения тактики лечения используется стратификация риска по международной прогностической шкале IPSET, учитывающая возраст ≥60 лет, количество лейкоцитов ≥11×10⁹/л, сердечно-сосудистые факторы риска (артериальную гипертензию, сахарный диабет, курение), наличие мутации и предшествующие тромботические события. На основании этих данных пациентов разделяют на группы низкого и высокого риска[5].
- Для группы низкого риска (молодые пациенты младше 60 лет без тромбозов в анамнезе) рекомендуется применение низких доз аспирина при отсутствии противопоказаний. Особую осторожность следует проявлять при уровне тромбоцитов выше 1000×10⁹/л из-за риска развития приобретённого синдрома фон Виллебранда. При выявлении лабораторных признаков этого синдрома или кровотечений аспирин противопоказан.
- Для группы высокого риска (возраст старше 60 лет и/или наличие тромбозов в анамнезе) показана комбинированная терапия, включающая низкие дозы аспирина и циторедуктивные препараты. Препаратом первой линии остаётся гидроксимочевина, эффективно снижающая количество тромбоцитов и лейкоцитов, что уменьшает риск тромбозов и замедляет развитие миелофиброза. Альтернативным средством является анагрелид, избирательно снижающий количество тромбоцитов за счёт угнетения мегакариоцитарной дифференцировки.
Особого внимания требует ведение беременных с ЭТ, у которых повышен риск потери плода в первом триместре и плацентарных осложнений. В этой группе рекомендовано применение низкомолекулярного гепарина в сочетании с низкими дозами аспирина (с отменой последнего при кровотечениях), а также циторедукция пегилированным интерфероном. Гидроксимочевина и анагрелид противопоказаны из-за тератогенного эффекта.
Для купирования эритромелалгии препаратом выбора остаётся аспирин. В педиатрической практике назначение аспирина требует особой осторожности из-за риска развития синдрома Рея[5].
Прогноз
ЭТ характеризуется относительно благоприятным течением, со средней продолжительностью жизни пациентов около 18 лет. Особенно хорошие показатели наблюдаются у пациентов младше 60 лет, где зарегистрирована ожидаемая продолжительность жизни до 33 лет. По сравнению с истинной полицитемией, прогноз при ЭТ более благоприятный. Однако, несмотря на в целом благоприятное течение заболевания, продолжительность жизни таких пациентов остаётся ниже, чем в общей популяции, что связано с риском развития потенциально опасных тромботических осложнений, которые могут существенно ухудшать прогноз[6].
Профилактика
Не разработана.
Примечания
Литература
- Мустяцэ Л. З., Пынзарь С. Г., Мустяцэ В. Г., Сгибнева-бобейко Н. В. К вопросу об эссенциальной тромбоцитемии // Гематология и трансфузиология. — 2022. — № S2.
- Жернякова А. А., Мартынкевич Ирина Степановна, Шуваев Василий Анатольевичч, Полушкина Любовь Борисовна, Волошин Сергей Владимирович, Бессмельцев Станислав Семёнович, Чечёткин Александр Викторович. Тромботические и геморрагические осложнения при эссенциальной тромбоцитемии // Вестник гематологии. — 2018. — № 1.
- Абдулкадыров К. М., Шуваев В. А., Мартынкевич И. С., Абдулкадырова А. С., Удальева В. Ю., Фоминых М. С., Головченко Р. А., Зотова И. И., Полушкина Л. Б., Чечёткин А. В. Эссенциальная тромбоцитемия: 10-летний анализ результатов наблюдений // Гематология и трансфузиология. — 2014. — № S1.